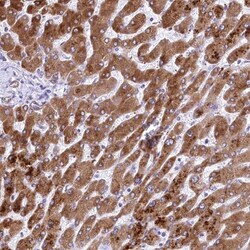
RDH16 Antibody, Novus Biologicals 0.1 mL | Buy Online | Novus Biologicals | Fisher Scientific

missing translation for 'onlineSavingsMsg'
Learn More
Learn More
Descrizione
RDH16 Polyclonal specifically detects RDH16 in Human samples. It is validated for Western Blot, Immunohistochemistry, Immunohistochemistry-Paraffin.

Specifica
Specifica
| Antigene | RDH16 |
| Applicazioni | Western Blot, Immunohistochemistry, Immunohistochemistry (Paraffin) |
| Classificazione | Polyclonal |
| Coniugato | Unconjugated |
| Diluizione | Western Blot 0.04-0.4 μg/mL, Immunohistochemistry 1:50 - 1:200, Immunohistochemistry-Paraffin 1:50-1:200 |
| Formulazione | PBS (pH 7.2) and 40% Glycerol with 0.02% Sodium Azide |
| N. accesso geni | O75452 |
| Alias gene | EC 1.1, EC 1.1.1, EC 1.1.1.105, Microsomal NAD+-dependent retinol dehydrogenase 4, retinol dehydrogenase 16, retinol dehydrogenase 16 (all-trans and 13-cis), retinol dehydrogenase 16 (all-trans), RODH4, RODH-4, SDR9C8, short chain dehydrogenase/reductase family 9C, member 8, Sterol/retinol dehydrogenase |
| Simboli geni | RDH16 |
| Specie ospite | Rabbit |
| Vedi altri risultati |
For Research Use Only
Titolo del prodotto
Facendo clic su Invia, l'utente riconosce che potrebbe essere contattato da Fisher Scientific in merito al feedback fornito in questo modulo. Non condivideremo le vostre informazioni per altri scopi. Tutte le informazioni di contatto fornite saranno conservate in conformità con la nostra Politica sulla privacy. Informativa sulla privacy.
Individuate un'opportunità di miglioramento?